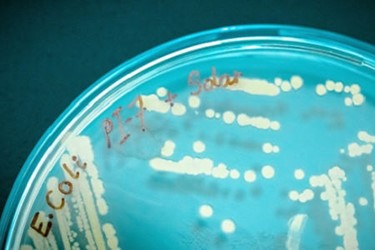
E. coli bacteriophage

Combining Forces To Combat E. coli PI-7
A combined treatment may help tackle the rise of E. coli PI-7 in Saudi Arabia’s wastewater systems.
Solar irradiation treatment, combined with naturally occurring viral components, could help destroy a highly antibiotic-resistant form of Escherichia coli (E. coli PI-7) that has been identified in Jeddah’s wastewater network.
Antibiotic resistance continues to develop rapidly in bacteria, which have evolving genes that can confer resistance through generations. One of these genes is the New Delhi metallo-β-lactamase gene, blaNDM, which E. coli PI-7 carries. Crucially, blaNDM confers resistance to antibiotics that are considered to be our last line of defense against certain diseases. This gene, and others like it, are found in increasing numbers in wastewater systems, which is a real concern for public health.
Bacteriophages are naturally occurring viruses that infiltrate and destroy bacteria by breaking down their cell membranes. As such, they represent a largely untapped source of agents that could help tackle antibiotic-resistant pathogens.
“Our previous study showed that solar irradiation helped partly destroy E. coli PI-7, but not eradicate it completely,” says Nada Al-Jassim, who has recently moved to Merck group after working on E. coli PI-7 under the supervision of Peiying Hong and her team at KAUST’s Water Desalination and Reuse Center. “Under solar irradiation, PI-7 cells can enhance their cellular wall and DNA repair mechanisms to protect themselves and survive. However, the mechanisms preventing phage infection were downregulated, suggesting a weakness in the bacteria that we could exploit.”
The team isolated seven bacteriophages from wastewater that specifically targeted PI-7—this was crucial to ensure the safety of the treatment in the wider environment.
“We selected three phages that remained stable under solar irradiation long enough to act on PI-7,” says Al-Jassim. “The phages slowed E. coli PI-7’s growth, downregulated cell wall functions and DNA repair, and limited the destruction of reactive oxygen species within the bacteria. In other words, the phages appear to actively exploit the bacteria’s own defense mechanisms.”
PI-7 cells treated with phages persisted for a shorter time under solar irradiation than untreated cells, suggesting that the phages increase PI-7’s sensitivity to sunlight. However, the team does not know how the combined treatment will fare in real wastewater treatment systems. For a start, coping with large volumes of water and maintaining phage concentrations under those conditions could prove challenging.
More pressing, however, Hong explains is that “regardless of the disinfection strategies, these techniques will cause the bacterium to release antibiotic resistance genes into the environment, where they could be taken up by other bacteria. We are keen to examine this in greater depth.”
References
Al-Jassim, N., Mantilla-Calderon, D., Scarascia, G. & Hong, P. Bacteriophages to sensitize a pathogenic New Delhi Metallo β-Lactamase-positive Escherichia coli to solar disinfection. Environmental Science and Technology 52, 14331–14341 (2018).| article
Source: King Abdullah University of Science and Technology (KAUST)
